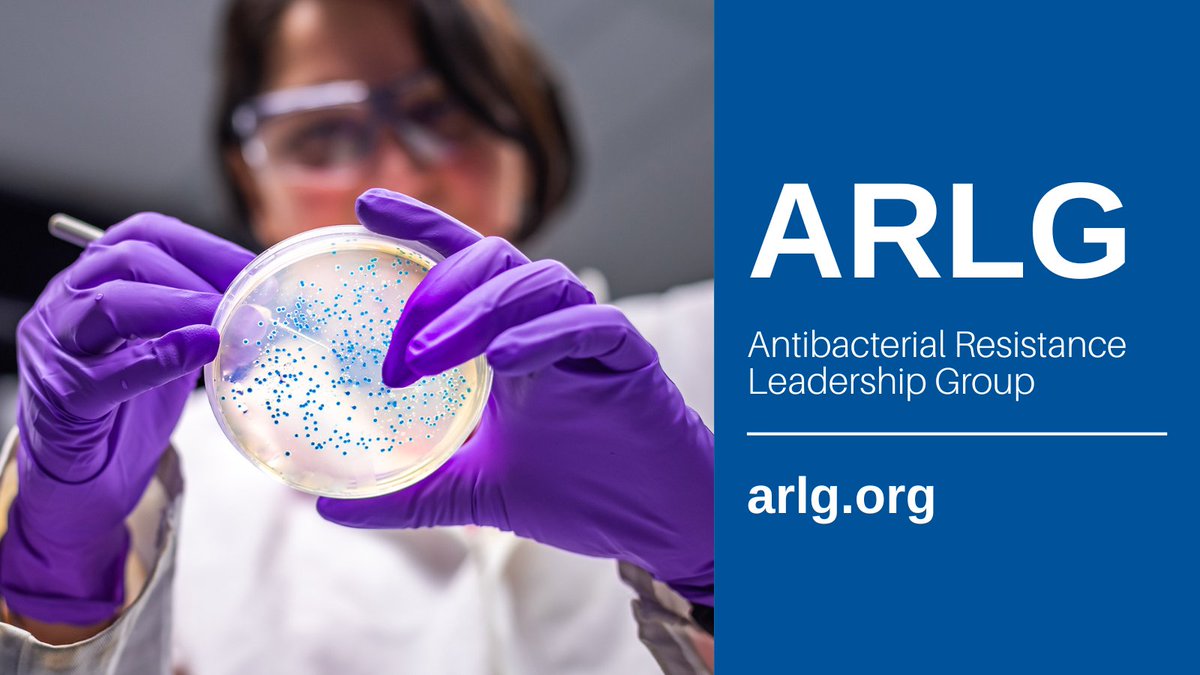
Antibacterial Resistance Leadership Group tweet media

The #ARLGnetwork SHREC study compared patients with E. coli blood infections susceptible to the antibiotic ceftriaxone to those with ceftriaxone-resistant infections. Learn how the study highlights the impact of #AMR on patient recovery: duke.is/ARLG-SHREC

English